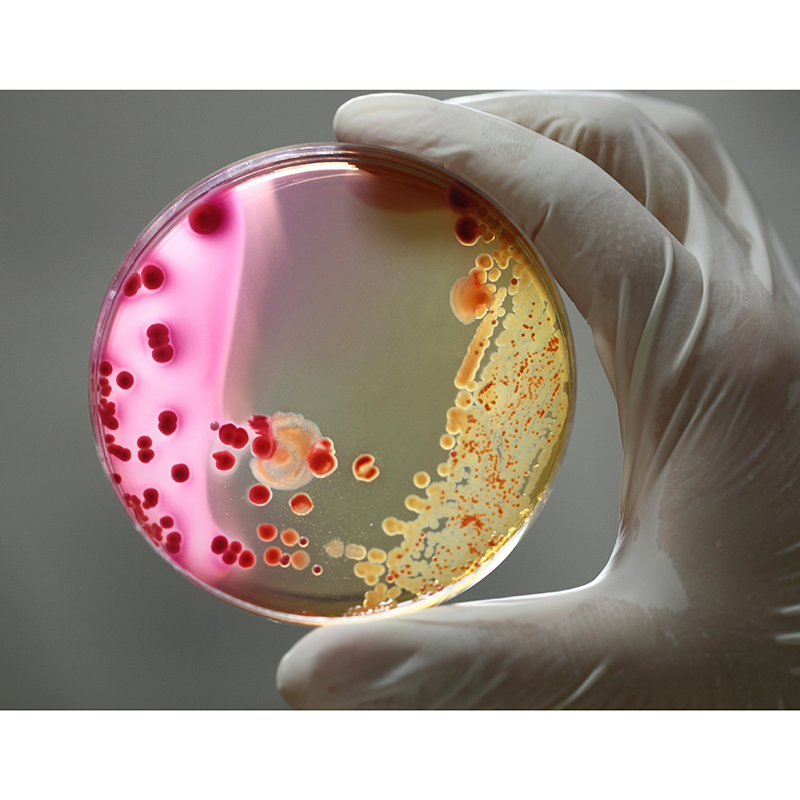

Engineering biology is one of the most exciting new frontiers in science. It describes the application of rigorous engineering principles to biology, enabling the construction of new or redesigned biological systems, such as cells or proteins. It has the potential to change the way we grow food, create medical treatments, and produce the sustainable fuel we need to run our cars, homes, and offices.
The UK Biosecurity Leadership Council, which meets for the first time on the 14th September, will help shape the way advances in engineering biology are governed, to guard against potential risks whilst ensuring the UK’s biology, health, and life science innovators are supported to explore, invent, and continue to thrive.
Engineering biology is one of the five critical technologies, which are all being nurtured by a single Government Department for the first time because of their strategic importance to the future prosperity and security of the UK. The UK’s engineering biology sector has the potential to grow at tremendous speed, driving forward the Prime Minister’s priority to grow the economy.
The Council will include representatives from top Universities like Kings College London and Cambridge, leaders from companies such as GSK, Deepmind, AstraZeneca, and Oxford Nanopore, and stakeholder groups including the UK Bioindustry Association, the Association of the British Pharmaceutical Industry, and the Centre for Long-Term Resilience.
Ahead of chairing the Council’s inaugural meeting, George Freeman, Minister of State at the Department for Science, Innovation and Technology said: “We are on the cusp of an engineering biology revolution, from therapies for previously untreatable illnesses to entirely new ways of recycling. This is an opportunity the UK is primed to capitalise on, whether by our world-leading expertise in life sciences or through the more than £170 million the Government is investing in the field.
“We are already seeing how this new sector can benefit our economy, with the UK founding more biotech companies than anywhere else in Europe. To make sure this position of strength delivers jobs, growth, and a better quality of life for all, now is the time for us to set the pace globally on how this new sector will be governed, empowering responsible innovation in the UK and worldwide.”
Deputy Prime Minister Oliver Dowden, said: “The Biosecurity Leadership Council brings together experts from our world-leading life sciences and biotechnology sectors here in the UK – vital in making sure we continue to drive scientific breakthroughs and manage biosecurity risks effectively.
“The inaugural meeting today shows we are already delivering on the Biological Security Strategy I announced just a few months ago, and that we are committed to keeping the public safe from bio-threats and maximising the benefits from our thriving life sciences industry.”
To begin with, the UK Biosecurity Leadership Council will support work on how the responsible development of DNA-based technology should be governed. Members of the Council will help Ministers and officials build their understanding of how industry-changing tools like AI and new techniques for engineering DNA are being used, the potential risks they pose, and how those can be mitigated in a practical and proportional way.
Establishing the Council was one of the objectives on the UK Biological Security Strategy, published in June, which sets out the Government’s overall plan to build our national resilience to future biological threats, whilst establishing the UK as a world leader in responsible innovation.
Steve Bates OBE, CEO of the UK BioIndustry Association (BIA), said: “Engineering biology has great potential and the diverse applications, making it a decisive force in tackling our world’s biggest challenges, from climate change to environmental degradation and feeding the growing global population.
“UK biotech companies have long understood the power that lies in combining biology with modern technology, driving our world-class life sciences sector, and leading advances in developing novel therapeutics and cell and gene therapies, and creating vaccines to fight the COVID-19 pandemic. Our long-standing expertise and experience mean the UK is well placed to safely and responsibly unlock the engineering biology revolution.”
Sophie Rose, Senior Biosecurity Policy Advisor at the Centre for Long-Term Resilience, said: “We praise the Government’s commitment to ensuring the UK set the example for empowering responsible innovation across emerging technology sectors, which is particularly crucial as life sciences and artificial intelligence advance at rapid paces.
“The Biosecurity Leadership Council is a great starting point to ensure that a wide range of relevant external expertise is readily available to address both acute and chronic biological risks.”
The Government is continuing to develop wider policy to support the huge potential of the UK’s engineering biology sector, and a call for evidence is still open until the end of September. Further to this, the latest in a series of roundtables is being hosted by Ministers today, bringing science leaders and businesses from across the country together with policymakers to look at how engineering biology can boost the UK’s chemicals and materials industries.